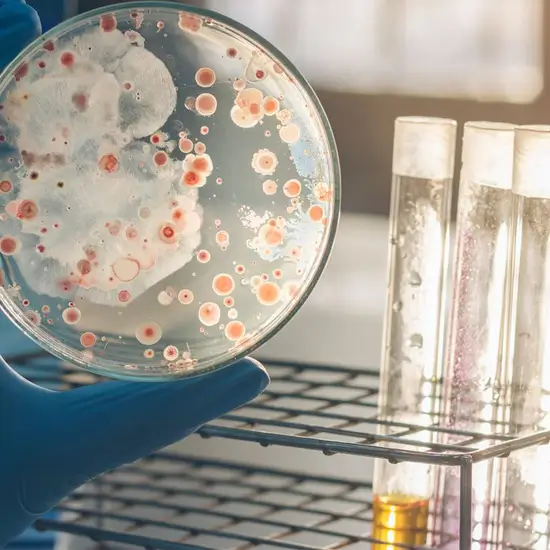

Book Cultured Anaerobic Appointment Online Near me at the best price in Delhi/NCR from Ganesh Diagnostic. NABL & NABH Accredited Diagnostic centre and Pathology lab in Delhi offering a wide range of Radiology & Pathology tests. Get Free Ambulance & Free Home Sample collection. 24X7 Hour Open. Call Now at 011-47-444-444 to Book your Cultured Anaerobic at 50% Discount.
Book Cultured Anaerobic Test at the best price in Delhi NCR, India from GDIC (Ganesh Diagnostic & Imaging Centre). GDIC is a NABL Accredited Pathology lab in Delhi offering a wide range of blood testing services.
What is Cultured Anaerobic Test?
This test looks for specific bacteria types in a wound or a fluid sample from an infection site. These bacteria are referred to as anaerobic because they do not require oxygen to grow. An anaerobic culture is one in which the test is performed without allowing oxygen to reach the sample.
Anaerobic bacteria infections can occur almost anywhere in your body. Infections in your mouth or lungs, diabetes-related foot infections, infected bites, and gangrene are all possibilities. Finding out which bacteria is causing your infection allows your doctor to prescribe the most appropriate treatment.
Why it is done?
This test may be performed if your healthcare provider needs to determine the type of bacteria causing an infection in your body. This test may be ordered by your provider based on the location of the wound, tissue damage, an unpleasant smelling wound, or an infection-related sore.
What is the procedure for Cultured Anaerobic Test?
A sample of fluid or tissue from your wound or sore is required for this test. Your healthcare provider may collect the sample with a cotton swab. They may also use a needle to extract fluid from your wound.
How does one prepare for the test?
You do not need any special preparation. However, make certain that your healthcare provider is aware of all medications.
Required Documents for
After Care:
No care is required.
The Cost Of Cultured Anaerobic Test In Delhi:
The Cultured Anaerobic Test costs vary by region and facility. So, get tested at trustworthy diagnostic centre like Ganesh Diagnostic. Training and experienced professionals are staffed to assure patient and visitor safety.
| Test Type | Cultured Anaerobic |
| Includes | Cultured Anaerobic - lab tests |
| Preparation | |
| Reporting | Within 24 Hours*. |
| Test Price |
₹ 1120
|

Early check ups are always better than delayed ones. Safety, precaution & care is depicted from the several health checkups. Here, we present simple & comprehensive health packages for any kind of testing to ensure the early prescribed treatment to safeguard your health.